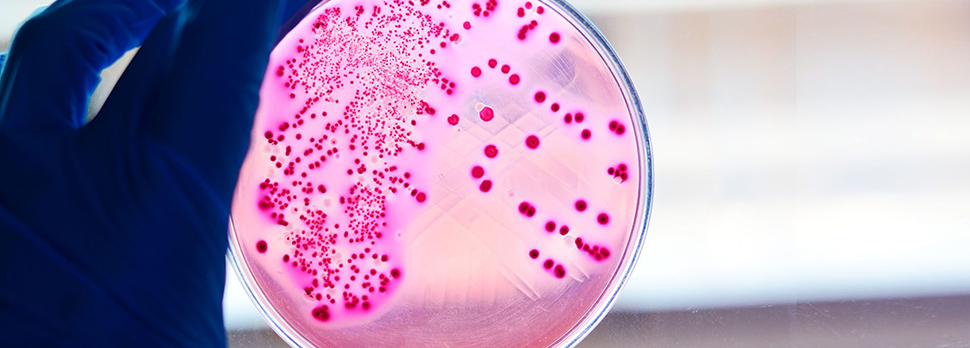

Em laboratórios de reprodução assistida, a precisão e a segurança começam muito antes da manipulação de gametas e embriões. A qualidade dos consumíveis, superfícies e meios de cultura tem impacto direto nos resultados, e um dos controles mais importantes nesse processo é o teste de endotoxinas.
Endotoxinas são capazes de comprometer a estabilidade do microambiente de cultura, prejudicar o desenvolvimento embrionário e causar falhas silenciosas difíceis de rastrear. Por isso, o controle rigoroso desses contaminantes é parte essencial do controle de esterilidade do laboratório.
Neste artigo, apresentamos os métodos mais utilizados para detecção de endotoxinas, os impactos na rotina e como a Ingámed integra essa análise aos certificados de seus produtos.
O que são endotoxinas e por que representam risco?
Endotoxinas são componentes da parede celular de bactérias Gram-negativas. Mesmo quando as bactérias já foram destruídas, essas toxinas permanecem ativas e podem causar danos significativos, pois:
- são resistentes ao calor e a processos comuns de desinfecção;
- alteram o comportamento e o metabolismo celular;
- prejudicam meios de cultura, óleos e soluções utilizadas no laboratório;
- interferem no desenvolvimento embrionário, mesmo em níveis muito baixos.
Em um laboratório de reprodução assistida, onde a sensibilidade é extrema, o controle rigoroso é indispensável.
Onde as endotoxinas podem estar presentes no laboratório?

Embora invisíveis a olho nu, endotoxinas podem ser encontradas em:
- consumíveis como tubos, pipetas, placas e cateteres;
- superfícies críticas como capelas, bancadas e incubadoras;
- meios de cultura e soluções manipuladas;
- utensílios e materiais de coleta e processamento.
Mesmo itens novos podem apresentar endotoxinas se não houver controle rigoroso no processo de fabricação. Por isso, a seleção de fornecedores confiáveis é parte essencial da qualidade.
Métodos mais utilizados nos testes de endotoxinas

1. Método LAL (Limulus Amebocyte Lysate)
Método LAL (Limulus Amebocyte Lysate) é o padrão ouro utilizado no mundo todo para a detecção de endotoxinas. Derivado de amebócitos do caranguejo ferradura (Limulus polyphemus), o LAL reage especificamente à presença de endotoxinas.
Ele pode ser aplicado de três maneiras:
- Gel-clot – indica presença/ausência (qualitativo);
- Turbidimétrico – mede a turvação (quantitativo);
- Cromogênico – mede variação de cor (quantitativo).
Ideal para consumíveis, meios de cultura, água preparada e materiais que entram em contato direto com embriões.
2. Testes rápidos para superfícies
Métodos de triagem usados para verificar rapidamente locais críticos, como:
- capelas de fluxo laminar;
- incubadoras e câmaras de aquecimento;
- bandejas e superfícies de manipulação.
Permitem intervenções rápidas antes que um problema afete a rotina.
3. Análise documental (CoA e validações)
Todo lote de produto sensível deve apresentar certificação clara com:
- valor máximo permitido de endotoxinas;
- método usado na análise;
- rastreabilidade do lote;
- resultados quantitativos ou qualitativos.
Essa etapa é fundamental para a validação de meios de cultura e consumíveis.
Impacto das endotoxinas na qualidade dos resultados laboratoriais

Endotoxinas podem causar problemas graves e silenciosos, como:
- queda nas taxas de fertilização;
- desenvolvimento embrionário lento ou irregular;
- aumento de fragmentação;
- falhas na transição para blastocisto;
- instabilidade do microambiente de cultura.
Por serem efeitos sutis e cumulativos, é comum que laboratórios só identifiquem o problema após muitas análises — reforçando a importância de testes consistentes.
Boas práticas de controle e prevenção

1. Controle de consumíveis
- Exigir certificados de baixa endotoxina para todos os itens críticos;
- Registrar lote, validade e fornecedor no sistema interno;
- Testar amostras antes de liberar lotes para uso clínico.
2. Higienização de superfícies críticas
- Protocolos diários de limpeza com produtos específicos;
- Monitoramento de capelas, incubadoras e áreas de cultura.
3. Validação interna de meios de cultura
- Testar cada lote recebido para verificar conformidade;
- Documentar resultados e comparar com históricos internos.
4. Monitoramento ambiental
- Controle de partículas e fluxo de ar;
- Verificação de temperatura e umidade;
- Auditorias regulares da rotina do laboratório.
Como a Ingámed garante controle rigoroso de endotoxinas

Na Ingámed, todos os produtos passam por testes de endotoxinas realizados internamente, garantindo:
- controle real da qualidade lote a lote;
- rastreabilidade completa;
- confiabilidade dos resultados;
- documentação consistente para auditorias.
Os valores e validações constam nos certificados que acompanham os produtos, facilitando o processo de inspeção e aprovação pelos laboratórios clientes.
Esse cuidado reflete o compromisso da Ingámed com segurança, transparência e qualidade técnica.
Exemplos práticos na rotina do laboratório

Situações em que o teste de endotoxinas é indispensável:
- Avaliação de um novo lote de placas para gota ou poço;
- Conferência de cateteres e consumíveis antes de ciclos sensíveis;
- Liberação de meios de cultura para FIV e ICSI;
- Controle de incubadoras após manutenção técnica;
- Revisão de laudos durante auditorias externas.
Essas ações preventivas garantem altos níveis de segurança e reduzem riscos silenciosos.
Conclusão
O teste de endotoxinas é um componente crítico do controle de qualidade laboratorial. Ele assegura que consumíveis, superfícies e meios utilizados na reprodução assistida estejam livres de contaminantes capazes de comprometer embriões e resultados clínicos.
Laboratórios que adotam processos rigorosos de validação e prevenção conquistam reprodutibilidade, segurança e previsibilidade nos ciclos.
A Ingámed reforça esse compromisso oferecendo produtos testados internamente e certificados com informações claras e auditáveis.